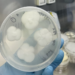
Engyodontium album.

Willow Announces Rollout of BioOxi Platform Providing Valuable and Expedited Bioconversion-Enabled Chemical Manufacturing
Willow Biosciences Inc. A leading biotechnology company focused on revolutionizing industrial manufacturing of pure, consistent and sustainable functional ingredients today announced the launch of BioOxi, a bio-oxidation platform technology that is complementary to the Company’s existing strain engineering and precision fermentation FutureGrown biotechnology platform. Through the Company’s legacy expertise, Willow is now able to offer commercial partners both cost-effective production of ingredients through biosynthesis, and now through BioOxi, bioconversion-enabled chemical manufacturing of ingredients from defined intermediates with the benefit of removing multiple chemical steps and significantly reducing cost and resources.
“The launch of BioOxi is an exciting development in the history of Willow and represents the next strategic step to significantly diversify our portfolio and market opportunities with a keen focus on nearer term revenue generation,” said, Dr. Chris Savile, Willow’s President and CEO. “We see this new platform as posing a powerful, clean and cost-effective solution to our prospective partners’ chemical manufacturing challenges that is highly complementary to our existing strain engineering and precision fermentation business. Based on our prior success in utilizing BioOxi to support our partners we believe it will lead to additional commercial agreements going forward.”
Willow successfully used its BioOxi platform in development programs for partners such as Kalsec Inc. for a previously announced November 2022 Master Services Agreement to develop and commercialize a precision fermentation production process for a high volume, natural food opportunity and, more recently, Willow further leveraged the successful application of BioOxi for engagements with Sandhill One, LLC to optimize a proprietary enzyme for a targeted product for the manufacturing of the large volume active pharmaceutical ingredient, ursodeoxycholic acid (UDCA).
By leveraging BioOxi, commercial partners can revolutionize manufacturing of oxygenated and hydroxylated functional ingredients such as steroids, polyphenols, oxyterpenes and certain other targeted ingredients produced from such methods.
The launch of BioOxi broadens Willow’s addressable total market opportunity and provides nearer-term revenue generation for BioOxi-related projects. Applications in this area take significantly less time to generate revenue as strain engineering applications and, in the Company’s belief, produce more longer-term and sometimes larger revenue streams. Both types of offerings can result in licensing or royalty revenues for Willow.
Willow will pursue BioOxi programs through both internal and external investment, through astutely planned and strategically aligned programs that the Company anticipates will expand its product portfolio and partnerships toward improved company valuation.
www.willowbio.com
#modernplasticsindia #plasticmagazine #indianmagazine #indianplasticmagazine #modernplasticsaward #ginujoseph #modernplastic #plasticindia #plasticnews #plasticrecycling #modernplasticsglobalnetwork #modernglobalnetwok #modernplasticsaward2023 #PlasticIndustry #willowbio